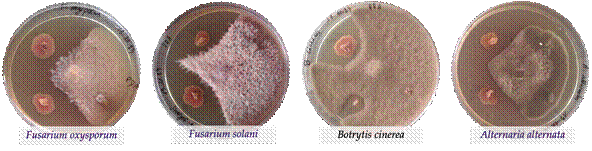

INTRODUCTION
The grapevine (Vitis vinifera L.) is one of the most economically important fruit crops worldwide (Grassi and De Lorenzis, 2021). In Portugal, the viticultural sector is central to the national economy, ranking third among the nation’s largest crop production (Costa et al., 2015). However, the grapevine is often affected by many fungal and viral diseases that are responsible for significant losses in the wine sector, and managing plant diseases has become a challenge for plant pathologists in more sustainable agriculture (Akhtar and Siddiqui, 2010). Using chemical pesticides and fertilizers causes hazardous effects on human health and the environment. Therefore, it is necessary to manage plant diseases and enhance crop production using eco-friendly methods and sources. Recently, beneficial microorganisms, including fungi and bacteria, have received increasing attention as a promising sustainable alternative to chemical fertilizers and pesticides (Wang et al., 2022). Plant growth-promoting bacteria (PGPB) play a vital role in managing plant diseases and directly and indirectly affect plant growth by producing several phytohormones, enzymes, siderophores, antibiotics, and solubilizing minerals (Akhtar and Siddiqui, 2010). The microbial diversity found in soil vineyards is a key determinant of grapevine growth and wine quality. Herein, this work aimed to isolate and characterize bacteria, with biofertilizer and biopesticide potential, from vineyards’ soils located in the Douro Wine Region. The isolated bacteria were tested for their antagonistic effects (biopesticide) against four phytopathogenic fungi including Fusarium oxysporum, F. solani, Botrytis cinerea, and Alternaria alternata. The antagonistic isolates were identified by 16S rDNA gene sequences and subjected to evaluating their plant growth-promoting properties (biofertilizer), including the ability to produce the indole-3-acetic acid (IAA), siderophores and solubilize phosphates.
MATERIAL AND METHODS
Isolation of Bacteria and Evaluation of Antagonistic Activity
The bacteria were isolated from three different samples, including leaves, berries, and soils of several grapevine varieties located in the Quinta do Ataíde (Symington), Vila Flor, Trás-os-Montes (Figure 1). The isolation was done by inoculating suspension solutions containing samples with autoclaved distilled water on Petri dishes with two culture media Trypticase Soy Agar (TSA) and Potato Dextrose Agar (PDA), separately. The plates were incubated at 25-28ºC. Then, the bacteria isolates were repeatedly subcultured onto fresh agar plates until getting a pure culture.
The purified bacteria isolates were used to evaluate their antagonistic effects (biopesticide) against four well-known selected phytopathogenic fungi namely Fusarium oxysporum, F. solani, Botrytis cinerea, and Alternaria alternata using the dual-culture method and PDA medium. The Petri dishes containing fungi and bacteria isolates were incubated at 28-30ºC for 7 days, and then the results were presented as distance (mm) between bacteria and pathogen edges.
Molecular Identification of Antagonistic Bacteria
The bacteria that showed the highest antagonistic activities against at least two pathogens were subjected to molecular identification. DNA extraction was done using the CTAB method, and 16S rDNA amplification was carried out with the primers 27F and 1942R (Laranjeira et al. 2021). The PCR products were sequenced by StabVida (Lisbon, Portugal) and compared with the GenBank nucleotide data bank from the National Center for Biotechnology Information (NCBI) using the Basic Local Alignment Search Tool (BLAST). Identification was performed by phylogenetic analysis using MEGA X software (Kumar et al., 2018).
Determination of the Plant Growth-Promotion Properties
Determination of the plant growth promotion properties (biofertilizer potential) was performed by evaluating the abilities of antagonistic bacteria to produce the indole-3-acetic acid (IAA), siderophores, and solubilize phosphates using the same procedures, equipment, and conditions used previously by Laranjeira et al. (2021).
The bacteria’s ability to produce IAA was estimated by colorimetric assay using the Salkowski reagent method (Patten and Glick, 2002). The IAA concentration was calculated using the calibration curve of pure IAA used as a standard.
The ability of bacteria to produce siderophore was tested qualitatively by the Chrome Azurol S assay (CAS) (Alexander and Zuberer, 1991). After incubation at 30ºC for 8 days, positive siderophore production was indicated by a colour change of the CAS medium from blue to orange.
For phosphate solubilizing ability, the antagonistic bacteria were evaluated for their ability to dissolve phosphate using the National Botanical Research Institute’s Phosphate (NBRIP) solid and liquid medium. For solid medium, tricalcium (TCP, Ca3(PO4)2) and aluminum (AlPO4) phosphates were used as single phosphorus sources, and the bacteria P-solubilizing activity was detected by the formation of a distinguished clear halo around the colonies (Mehta and Nautiyal, 2001; Laranjeira et al., 2021). Concerning the liquid medium, TCP was used as the only phosphate source to quantify P-solubilization by measuring the level of free phosphate, and pH values, and calculating the efficiency of P-solubilization (Suleimanova et al., 2023).
RESULTS AND DISCUSSION
Antagonistic bacteria and their molecular identification
More than 120 bacteria were isolated from vineyard samples, and most of them were isolated from berries and soils. These isolates were evaluated for their antagonistic effect against four well-known phytopathogenic fungi: F. oxysporum, F. solani, B. cinerea, and A. alternata (Figure 2). Thirty among them were chosen to present their results in this work, as they exhibited high antagonistic activity. These antagonistic isolates were identified through molecular techniques, and their plant growth-promoting properties were tested.
Figure 2 Example of bacteria isolates showing strong antagonistic effects against the four phytopathogenic fungi.
The molecular identification using 16S rDNA sequence revealed the presence of 7 bacteria genera, namely Bacillus, Streptomyces, Burkholderia, Calidifontibacillus, Paenibacillus, Priestia, and Alcaligenes, whereas, most identified species belong to Bacillus, particularly B. subtilis and B. amyloliquefaciens species.
The isolates Gs3 (Burkholderia sp.), 42s5 (Streptomyces sp.), Qs6 (Alcaligenes sp.), Cb5 (Paenibacillus sp.), and Nb4 (Bacillus sp.) showed the highest antifungal effect. Generally, F. oxysporum was the more bacteria resistant phytopathogenic fungi, while A. alternata was the most sensitive. The strong antagonistic activity of isolated bacteria may be due to these bacteria being able to synthesize biologically active compounds with high antifungal properties (Ranjbariyan et al., 2011). Overall, these findings showed that vineyards are an important source of beneficial bacteria able to eco-friendly manage several plant diseases.
Plant Growth-Promotion Properties of Antagonistic Bacteria
According to, the obtained data on the production ability of indole-3-acetic acid (IAA), all 30 antagonistic bacteria showed the ability to produce IAA with values ranging between 1.5 and 53 𝜇g/mL. The isolate Gs3 (Burkholderia sp.) was the one with the highest capability to produce IAA, followed by Cs4 (Priestia sp.) and Nb1 (Bacillus sp.).
The qualitative determination of siderophore production by isolated bacteria was done by CAS assay, and results demonstrated that all bacteria were able to produce siderophores by developing a yellow halo around inoculated isolates. The most efficient isolates were Nb4 (Bacillus sp.), 42s3 (Bacillus sp.), and Qs6 (Alcaligenes sp.). Generally, the Bacillus species showed better results than other isolates.
The phosphate solubilization ability of the studied bacteria was evaluated qualitatively on solid medium and quantitively in liquid medium to confirm their capacity to solubilize phosphate. Concerning the solid medium, the results were highly variable among the isolates, where some bacteria showed well-developed halo zones on plates containing TCP, particularly Burkholderia sp. (Gs3), while the other bacteria only changed the colour of the medium. None of the bacteria studied formed halos on plates containing AlPO4. Based on qualitative results, the TCP was chosen as a source of phosphate to quantify the P-solubilisation using NBRIP liquid medium. The quantification results showed that all antagonistic bacteria had the capacity for solubilizing the TCP with concentrations varying between 85 and 800 𝜇g/mL, whereas Gs3 (Burkholderia sp.) was the highest-produced isolate followed by the isolates 42s5 (Streptomyces sp.) and Cb5 (Paenibacillus sp.) (Figure 3). The phosphate solubilization was accompanied by an acidification of the medium, which is likely due to the important production of organic acids.

Figure 3 Inorganic phosphate solubilization ability of the 30 bacteria isolates in NBRIP liquid medium with TCP (tricalcium phosphate) as phosphate sources, after 4 and 8 days of incubation.
Generally, the antagonistic bacteria in the current work showed high capacities of producing phytohormone (IAA) and organic compounds (including siderophores, organic acids, etc.) and solubilization of inorganic phosphates, which positively influence plant growth and development and play an important role in the suppression of plant pathogens.
CONCLUSION
In summary, the results demonstrated that vineyards soils in the Douro Wine Region (Portugal) are a rich source of beneficial bacteria, which showed interesting results as biofertilizers and biopesticides. These beneficial bacteria can be suggested as a sustainable alternative to agrochemicals. However, further studies are required to evaluate their properties in field conditions, separately and/or in combination, aiming to develop commercial products.














